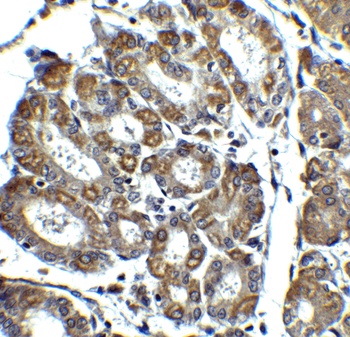
Pmaip1 Antibody

You have no items in your shopping cart.
Phorbol 12-myristate 13-acetate
SKU: orb1296136
Description
Research Area
Epigenetics & Chromatin, Pharmacology & Drug Discovery, Signal Transduction
Customer Validated Data
− The data below is submitted by researchers worldwide. We provide this transparency to help you decide if this product works for your specific application or species, even if we haven't tested it ourselves.
Success by Application
Reactivity Distribution
Latest Experiments
5 ResultsDilution
Sample
Summary
Cell culture
Human
1 µM
C28/I2 cell line
C28/I2 cells were treated with a...
Cell culture
Mouse
50 ng/mL
Naive CD4⁺ T cells isolated from the spleens of adult mice.
Naive CD4⁺ T cells were first...
Cell culture
Human
-
iPSC-derived NK (iNK) cells
1×10⁶ iNK cells are seeded and...
Induce cell differentiation
Human
100 ng/mL
THP-1 human leukemia monocytic cell line
THP-1 cells are cultured and treated...
Cell culture
Mouse
5 ng/mL
T cells isolated from both the spleen and tumor tissues of C57BL/6J mice
Isolated T cells are incubated in...
Images & Validation
−
Key Properties
−| CAS Number | 16561-29-8 |
|---|---|
| MW | 616.83 |
| Purity | >99.99% (May vary between batches) |
| Formula | C36H56O8 |
| SMILES | [H][C@]12[C@]3([H])C=C(CO)C[C@]4(O)C(=O)C(C)=C[C@@]4([H])[C@@]3(O)[C@H](C)[C@@H](OC(=O)CCCCCCCCCCCCC)[C@@]1(OC(C)=O)C2(C)C |
| Target | PKC,NF-κB,S1P Receptor |
| Solubility | DMSO: 60 mg/mL (97.27 mM), Sonication is recommended. H2O: Insoluble |
Bioactivity
−| Target IC50 | |
|---|---|
| In Vivo | |
| In Vitro | |
| Cell Research | |
| Animal Research |
Storage & Handling
−| Storage | keep away from direct sunlight,store under nitrogen,store at low temperature,keep away from moisture | Powder: -20°C for 3 years | In solvent: -80°C for 1 year | Shipping with blue ice/Shipping at ambient temperature. |
|---|---|
| Expiration Date | 12 months from date of receipt. |
| Disclaimer | For research use only |
Alternative Names
−Protein kinase C, S1PReceptor, S1P Receptor, TPA, SphK, Sphingosine kinase, PKC, Phorbol 12 myristate 13 acetate, Phorbol 12-myristate, Phorbol 12myristate 13acetate, Phorbol 12-myristate 13-acetate, Phorbol myristate, Nuclear factor-kappaB, Nuclear factor-κB, PMA, NFκB, NF-κB, NFkB, NF-kB, Inhibitor, inhibit
Similar Products
−Pmaip1 Antibody [orb1238793]
ELISA, IF, IHC-P, WB
Human, Mouse, Rat
Rabbit
Polyclonal
Unconjugated
0.1 mg, 0.02 mgNOXA Rabbit Polyclonal Antibody [orb412881]
IF, WB
Human, Mouse, Rat
Rabbit
Polyclonal
Unconjugated
50 μl, 100 μl, 200 μl, 30 μl

Quality Guarantee
Explore bioreagents carefree to elevate your research. All our products are rigorously tested for performance. If a product does not perform as described on its datasheet, our scientific support team will provide expert troubleshooting, a prompt replacement, or a refund. For full details, please see our Terms & Conditions and Buying Guide. Contact us at support@biorbyt.com.
Compound Identifiers
PubChem CID
Key Properties
− No computed properties available.
Documents Download
Datasheet
Product Information
Request a Document
Protocol Information
Phorbol 12-myristate 13-acetate (orb1296136)
Based on 0 reviews
Participating in our Biorbyt product reviews program enables you to support fellow scientists by sharing your firsthand experience with our products.
Login to Submit a Review